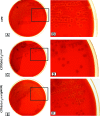

Hemolysin of uropathogenic Escherichia coli evokes extensive shedding of the uroepithelium and hemorrhage in bladder tissue within the first 24 hours after intraurethral inoculation of mice
- PMID: 18443089
- PMCID: PMC2446707
- DOI: 10.1128/IAI.00075-08
Hemolysin of uropathogenic Escherichia coli evokes extensive shedding of the uroepithelium and hemorrhage in bladder tissue within the first 24 hours after intraurethral inoculation of mice
Abstract
Many uropathogenic Escherichia coli (UPEC) strains produce both hemolysin (Hly) and cytotoxic necrotizing factor type 1 (CNF1), and the loci for these toxins are often linked. The conclusion that Hly and CNF1 contribute to urovirulence is supported by the results of epidemiological studies associating the severity of urinary tract infections (UTIs) with toxin production by UPEC isolates. Additionally, we previously reported that mouse bladders and rat prostates infected with UPEC strain CP9 exhibit a more profound inflammatory response than the organs from animals challenged with CP9cnf(1) and that CNF1 decreases the antimicrobial activities of polymorphonuclear leukocytes. More recently, we created an Hly mutant, CP9Delta hlyA(1)::cat, and showed that it was less hemolytic and destructive for cultured bladder cells than CP9 was. Here we evaluated the relative effects of mutations in hlyA(1) or cnf(1) alone or together on the pathogenicity of CP9 in a mouse model of ascending UTI. To do this, we constructed an hlyA(1)-complemented clone of CP9Delta hlyA(1)::cat and an hlyA(1) cnf(1) CP9 double mutant. We found that Hly had no influence on bacterial colonization of the bladder or kidneys in single or mixed infections with the wild type and CP9Delta hlyA(1)::cat but that it did provoke sloughing of the uroepithelium and bladder hemorrhage within the first 24 h after challenge. Finally, we confirmed that CNF1 expression induces bladder inflammation and, in particular, as shown in this study, submucosal edema. From these data, we speculate that Hly and CNF1 may be largely responsible for the signs and symptoms of cystitis in humans infected with toxigenic UPEC.
Figures

References
-
- Aktories, K. 1997. Rho proteins: targets for bacterial toxins. Trends Microbiol. 5282-288. - PubMed
-
- Alonso, P., J. Blanco, M. Blanco, and E. A. Gonzalez. 1987. Frequent production of toxins by Escherichia coli strains isolated from human urinary tract infections: relation with haemagglutination. FEMS Microbiol. Lett. 48391-396.
-
- Andreu, A., A. E. Stapleton, C. Fennell, H. A. Lockman, M. Xercavins, F. Fernandez, and W. E. Stamm. 1997. Urovirulence determinants in Escherichia coli strains causing prostatitis. J. Infect. Dis. 176464-469. - PubMed
-
- Blanco, J., M. P. Alonso, E. A. Gonzalez, M. Blanco, and J. I. Garabal. 1990. Virulence factors of bacteraemic Escherichia coli with particular reference to production of cytotoxic necrotising factor (CNF) by P-fimbriate strains. J. Med. Microbiol. 31175-183. - PubMed
-
- Blanco, J., M. Blanco, M. P. Alonso, J. E. Blanco, E. A. Gonzalez, and J. I. Garabal. 1992. Characteristics of haemolytic Escherichia coli with particular reference to production of cytotoxic necrotizing factor type 1 (CNF1). Res. Microbiol. 143869-878. - PubMed
Publication types
MeSH terms
Substances
Grants and funding
LinkOut - more resources
Full Text Sources
Miscellaneous